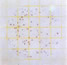

![]() |
3M 乳酸菌測試片操作以及判讀
|
|
2*MRS的操作步驟
|
|
1、按說明書要求的2倍用量制備2×MRS肉湯。例如:如果說明書要求1L水中加入55gMRS,則2×MRS則為1L水中加入110gMRS. |
2、用標準稀釋液制備1:10樣品稀釋液,該樣品稀釋液可用于檢測其他微生物。 |
3、用1mL 3M電子加樣器將1:10樣品稀釋液做1:2稀釋。先取0.5mL肉2×MRS肉湯,然后再吸取0.5mL 1:10樣品稀釋液,混勻后即可獲得含單倍 MRS的1:20樣品稀釋液。 |
4、接種:在PAC檢測片上接種1mL 1:20樣品稀釋液(0.5mL 1:10標準稀釋液+0.5mL 2×MRS肉湯=1:20含單倍MRS的樣品稀釋液)。 |
5、培養(yǎng):厭氧培養(yǎng)測試片。將檢測片透明膜一面朝上放入?yún)捬豕拗,疊放數(shù)量不得超過20片。如果檢測片超過20片,可在同一罐中用一個堅硬的分隔器將檢測片分開培養(yǎng)。將厭氧罐放入30℃~35℃(86℃~95℉)培養(yǎng)箱中培養(yǎng)48+3h. |
6、判讀:PAC測試片可在標準菌落計數(shù)器或其他放大光源下計數(shù)。測試片賞的菌落數(shù)×稀釋倍數(shù)(20)即為每毫升樣品中酸乳菌數(shù)。詳見判讀手冊。 |
| 4*MRS肉湯的操作程序 | |
| 1、 按說明書要求的4倍用量制備4*MRS肉湯 2、 用標準稀釋液制備1:10樣品稀釋液(11g/99mL或25g/225mL)。取8mL供其它種類的微生物檢測用。 3、 將4*MRS肉湯加入1:10標準樣品稀釋液中,將獲得含0.5 MRS的樣品稀釋液。 * 如果稀釋液中含有11g樣品、99mL標準稀釋液,接種其它微生物測試片后,再加入18mL 4*MRS肉湯。 PAC測試片上生長的菌落數(shù)乘以11即為最終結(jié)果(個/g)。 * 如果稀釋液中含有25g樣品、255mL標準稀釋液,接種其它微生物檢測片后,再加入41mL 4*MRS肉湯。 PAC測試片上生長的菌落數(shù)乘以11即為最終結(jié)果(個/g)。 |
|
1、制備至少1:10或更高稀釋度的樣品稀釋液。稱量食品樣品于WirPak取樣袋、均質(zhì)袋、稀釋瓶或其它適合的消容器中。 |
2、加入適當?shù)娜鉁♂屢海♂屢旱呐渲梅椒ǜ鶕?jù)說明書制備。如果使用一種1:10稀釋液檢測多種微生物,3M公司提供了更為簡便的多種菌檢測程序(見前頁)。 |
3、如果需要進行多倍稀釋,肉湯稀釋液只能用于最終稀釋步驟。初始稀釋可使用標準稀釋液,包括磷酸鹽緩沖液(ID)F磷酸鹽緩沖液,0.0425g/L KH2POI4 Ph7.2) 、0.1%蛋白膠水,蛋白膠鹽稀釋液(ISO方法6887)、蛋白膠水緩沖液(ISO方法6579)、生理鹽水(0.85~0.90%),不含亞硫酸氫鹽的 Letheen肉湯或蒸餾水,每步稀釋都應充分混勻。 |
4、接種:按操作說明接種1.0mL樣品稀釋液于Petrifilm |
5、培養(yǎng):厭氧培養(yǎng)測試片。將測試片透明面朝上放入GASPak厭氧罐中,疊放數(shù)量不得超過20片。如果檢測片超過20片,可在同一罐中用一個堅硬的分隔器將檢測片分開培養(yǎng)。將厭氧罐放入30℃~35℃(86℉~95℉)培養(yǎng)箱中培養(yǎng)48+3h. |
6、判讀:Petrifilm: PAC測試片可在標準菌落計數(shù)器或其他放大光源下計數(shù)。測試片賞的菌落數(shù)乘以稀釋倍數(shù),可獲得每毫升樣品中酸乳菌落數(shù)。詳見判讀手冊。 |
| 判讀手冊 | |
Count=238使用PAC測試片,用MRS肉湯稀釋樣品和厭養(yǎng),可促進同型發(fā)酵的乳酸菌生長. 圖1為同型發(fā)酵的乳酸菌落(不帶氣泡)的例子. |
Count=30測試片中有導型發(fā)家哦的乳酸菌(產(chǎn)氣)和同型發(fā)酵的乳酸菌.用MRS肉湯稀釋, 使異型發(fā)酵的乳酸菌在暗影背景下有明顯氣泡產(chǎn)生(見黑圈1) 生長區(qū)邊緣的異型發(fā)酵乳酸菌菌落大約在1/4英寸時,可能不產(chǎn)生可視的氣泡(見黑圈2). |
Count=0圖3是用MRS內(nèi)湯為稀釋液接種PAC測試片作為對照,以MRS為稀釋液及厭氧培養(yǎng)將在測試片上產(chǎn)生一個稍顯暗色的淺色圓形生長區(qū)域. |
Count=60測試片最適宜計數(shù)范圍是25-250個菌落,計數(shù)所有菌落,不管其大小和顏色深淺. |
Estimated count=440 測試片面積約為20cm2 .當菌落數(shù)超過250個(如圖5所示)時,可估算菌落數(shù).選擇其中一個或數(shù)個有代表性菌落的小方格(1cm2 ),計算平均菌落數(shù),在乘以20可得到測試片上的菌落總數(shù). |
Count=TNTC(Estimated count=106)當菌落數(shù)多不可計(tntc)時,整個生長區(qū)可能變?yōu)榉奂t色,如圖6所示.將測試片與以MRS肉湯作對照的測試片做比較,因為測試片的顏色變化是微小的(見圖3),此種情況下樣品需作進一步稀釋. |
Count=TNTC(Estimated count=106)仔細觀察,在測試片生長區(qū)中心和邊緣處可見針尖大小的菌落,計錄為TNTC結(jié)果. |
Conut=TNTC(Estimated count=108)當菌落數(shù)很多時,許多針尖大小的菌落會環(huán)繞在生長區(qū)邊緣,記錄為TNTC. |
Count=TNTC圖9是TNTC的又一個例子.同型發(fā)酵乳酸菌菌落(無氣泡產(chǎn)生)(黑圈1)與異型發(fā)酵乳酸菌菌落(有氣泡產(chǎn)生)(黑圈2)同時出現(xiàn). |
Count=52人為的氣泡可能是不適當?shù)慕臃N所致,他們形狀不規(guī)則,且不與菌落相連接 |
手機版

1、按說明書要求的2倍用量制備2×MRS肉湯。例如:如果說明書要求1L水中加入55gMRS,則2×MRS則為1L水中加入110gMRS.
2、用標準稀釋液制備1:10樣品稀釋液,該樣品稀釋液可用于檢測其他微生物。
3、用1mL 3M電子加樣器將1:10樣品稀釋液做1:2稀釋。先取0.5mL肉2×MRS肉湯,然后再吸取0.5mL 1:10樣品稀釋液,混勻后即可獲得含單倍 MRS的1:20樣品稀釋液。
4、接種:在PAC檢測片上接種1mL 1:20樣品稀釋液(0.5mL 1:10標準稀釋液+0.5mL 2×MRS肉湯=1:20含單倍MRS的樣品稀釋液)。
5、培養(yǎng):厭氧培養(yǎng)測試片。將檢測片透明膜一面朝上放入?yún)捬豕拗,疊放數(shù)量不得超過20片。如果檢測片超過20片,可在同一罐中用一個堅硬的分隔器將檢測片分開培養(yǎng)。將厭氧罐放入30℃~35℃(86℃~95℉)培養(yǎng)箱中培養(yǎng)48+3h.
6、判讀:PAC測試片可在標準菌落計數(shù)器或其他放大光源下計數(shù)。測試片賞的菌落數(shù)×稀釋倍數(shù)(20)即為每毫升樣品中酸乳菌數(shù)。詳見判讀手冊。
1、制備至少1:10或更高稀釋度的樣品稀釋液。稱量食品樣品于WirPak取樣袋、均質(zhì)袋、稀釋瓶或其它適合的消容器中。
2、加入適當?shù)娜鉁♂屢海♂屢旱呐渲梅椒ǜ鶕?jù)說明書制備。如果使用一種1:10稀釋液檢測多種微生物,3M公司提供了更為簡便的多種菌檢測程序(見前頁)。
3、如果需要進行多倍稀釋,肉湯稀釋液只能用于最終稀釋步驟。初始稀釋可使用標準稀釋液,包括磷酸鹽緩沖液(ID)F磷酸鹽緩沖液,0.0425g/L KH2POI4 Ph7.2) 、0.1%蛋白膠水,蛋白膠鹽稀釋液(ISO方法6887)、蛋白膠水緩沖液(ISO方法6579)、生理鹽水(0.85~0.90%),不含亞硫酸氫鹽的 Letheen肉湯或蒸餾水,每步稀釋都應充分混勻。
4、接種:按操作說明接種1.0mL樣品稀釋液于Petrifilm
5、培養(yǎng):厭氧培養(yǎng)測試片。將測試片透明面朝上放入GASPak厭氧罐中,疊放數(shù)量不得超過20片。如果檢測片超過20片,可在同一罐中用一個堅硬的分隔器將檢測片分開培養(yǎng)。將厭氧罐放入30℃~35℃(86℉~95℉)培養(yǎng)箱中培養(yǎng)48+3h.
6、判讀:Petrifilm: PAC測試片可在標準菌落計數(shù)器或其他放大光源下計數(shù)。測試片賞的菌落數(shù)乘以稀釋倍數(shù),可獲得每毫升樣品中酸乳菌落數(shù)。詳見判讀手冊。
Count=238
Count=30
Count=0
Count=60
Estimated count=440
Count=TNTC(Estimated count=106)
Count=TNTC(Estimated count=106)
Conut=TNTC(Estimated count=108)
Count=TNTC
Count=52

